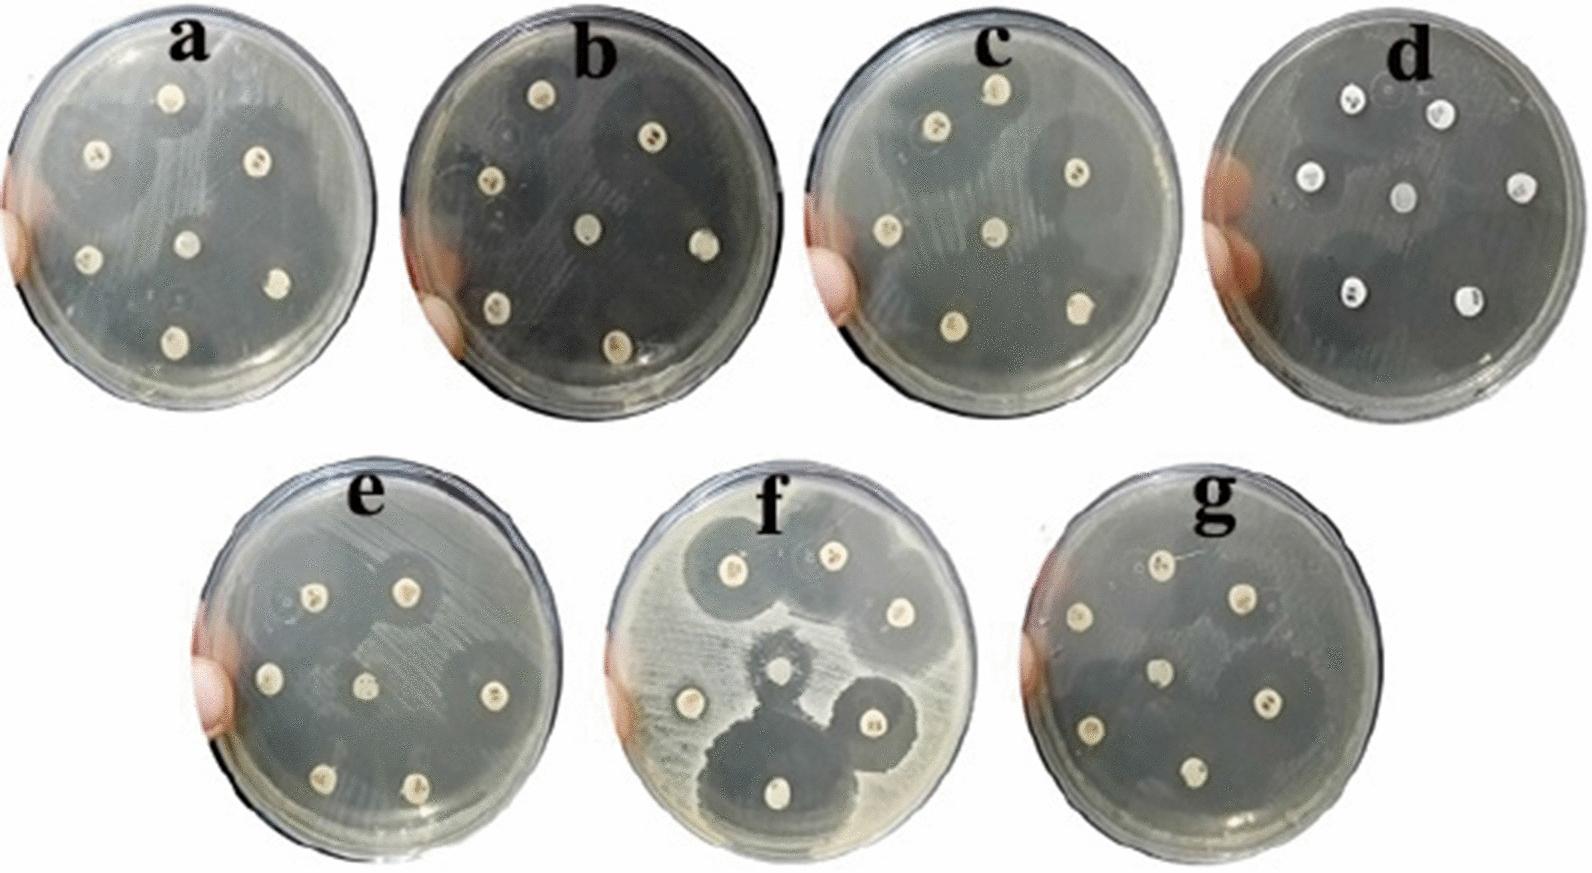
https://cdn.ncbi.nlm.nih.gov/pmc/blobs/365d/9801658/9030ce933dc4/12934_2022_1998_Fig18_HTML.jpg

利用肠杆菌属(Leclercia adecarboxylata)THHM 进行细胞外生物合成、OVAT/统计优化和银纳米粒子(AgNPs)的表征及其抗菌活性。
Extracellular biosynthesis, OVAT/statistical optimization, and characterization of silver nanoparticles (AgNPs) using Leclercia adecarboxylata THHM and its antimicrobial activity.
机构信息
Microbiology Department, Faculty of Science, Ain Shams University, Cairo, Egypt.
Environmental Biotechnology Department, Genetic Engineering and Biotechnology Research Institute (GEBRI), City of Scientific Research and Technological Applications (SRTA-City), New Borg El-Arab City, Alexandria, 21934, Egypt.
出版信息
Microb Cell Fact. 2022 Dec 30;21(1):277. doi: 10.1186/s12934-022-01998-9.
BACKGROUND
The biosynthesis of silver nanoparticles (AgNPs) is an area of interest for researchers due to its eco-friendly approach. The use of biological approaches provides a clean and promising alternative process for the synthesis of AgNPs. We used for the first time the supernatant of Leclercia adecarboxylata THHM under optimal conditions to produce AgNPs with an acceptable antimicrobial activity against important clinical pathogens.
RESULTS
In this study, soil bacteria from different locations were isolated and screened for their potential to form AgNPs. The selected isolate, which was found to have the ability to biosynthesize AgNPs, was identified by molecular methods as Leclercia adecarboxylata THHM and its 16S rRNA gene was deposited in GenBank under the accession number OK605882. Different conditions were screened for the maximum production of AgNPs by the selected bacteria. Five independent variables were investigated through optimizations using one variable at a time (OVAT) and the Plackett-Burman experimental design (PBD). The overall optimal parameters for enhancing the biosynthesis of AgNPs using the supernatant of Leclercia adecarboxylata THHM as a novel organism were at an incubation time of 72.0 h, a concentration of 1.5 mM silver nitrate, a temperature of 40.0 °C, a pH of 7.0, and a supernatant concentration of 30% (v/v) under illumination conditions. The biosynthesized AgNPs have been characterized by UV-visible spectroscopy (UV-Vis), transmission electron microscopy (TEM), and Fourier transform infrared spectroscopy (FTIR). The biosynthesized AgNPs showed an absorption peak at 423 nm, spherical shape, and an average particle size of 17.43 nm. FTIR shows the bands at 3321.50, 2160.15, and 1636.33 cm corresponding to the binding vibrations of amine, alkyne nitrile, and primary amine bands, respectively. The biosynthesized AgNPs showed antimicrobial activity against a variety of microbial pathogens of medical importance. Using resazurin-based microtiter dilution, the minimum inhibitory concentration (MIC) values for AgNPs were 500 µg/mL for all microbial pathogens except for Klebsiella pneumoniae ATCC13883, which has a higher MIC value of 1000 µg/mL.
CONCLUSIONS
The obtained data revealed the successful green production of AgNPs using the supernatant of Leclercia adecarboxylata THHM that can be effectively used as an antimicrobial agent against most human pathogenic microbes.
背景
由于其环保方法,银纳米粒子(AgNPs)的生物合成是研究人员感兴趣的领域。使用生物方法为 AgNPs 的合成提供了一种清洁且有前景的替代工艺。我们首次使用最佳条件下的 Leclercia adecarboxylata THHM 的上清液来生产具有可接受的抗重要临床病原体抗菌活性的 AgNPs。
结果
在这项研究中,从不同地点分离并筛选了土壤细菌,以研究其形成 AgNPs 的潜力。通过分子方法鉴定出具有生物合成 AgNPs 能力的选定分离株为 Leclercia adecarboxylata THHM,并将其 16S rRNA 基因在 GenBank 中以 OK605882 登录号进行了注册。通过一次筛选一个变量的 OVAT 和 Plackett-Burman 实验设计(PBD)筛选了最大程度生产 AgNPs 的最佳条件。使用 Leclercia adecarboxylata THHM 的上清液作为新型生物体,通过优化研究了五个独立变量。在光照条件下,最佳的生物合成 AgNPs 的总体优化参数为孵育时间为 72.0 h,硝酸银浓度为 1.5 mM,温度为 40.0°C,pH 值为 7.0,上清液浓度为 30%(v/v)。通过紫外-可见光谱(UV-Vis)、透射电子显微镜(TEM)和傅里叶变换红外光谱(FTIR)对生物合成的 AgNPs 进行了表征。生物合成的 AgNPs 在 423nm 处显示出吸收峰,呈球形,平均粒径为 17.43nm。FTIR 显示出 3321.50、2160.15 和 1636.33cm 处的带,分别对应于胺、炔腈和伯胺带的结合振动。生物合成的 AgNPs 对多种重要医学微生物病原体具有抗菌活性。使用 Resazurin 微量稀释法,AgNPs 的最小抑菌浓度(MIC)值除了对肺炎克雷伯菌 ATCC13883 为 1000μg/mL 外,对所有微生物病原体均为 500μg/mL。
结论
获得的数据表明,成功地使用 Leclercia adecarboxylata THHM 的上清液绿色生产了 AgNPs,可有效用作抗大多数人类致病微生物的抗菌剂。